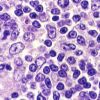

|
|
Thymus, rat - histology slide
|
|

Thymus - histology slide
|
|

Thymus - histology slide
|
|

Thymus - histology slide
|
|

Thymus - histology slide
|
|

Thymus - histology slide
|
|

Thymus - histology slide
|
|

Thymus - histology slide
|
|

Thymus - histology slide
|
|

Thymus - histology slide
|
|

Thymus - histology slide
|
|

Thymus - histology slide
|
|
| 48 files on 4 page(s) |
1 |
 |
|